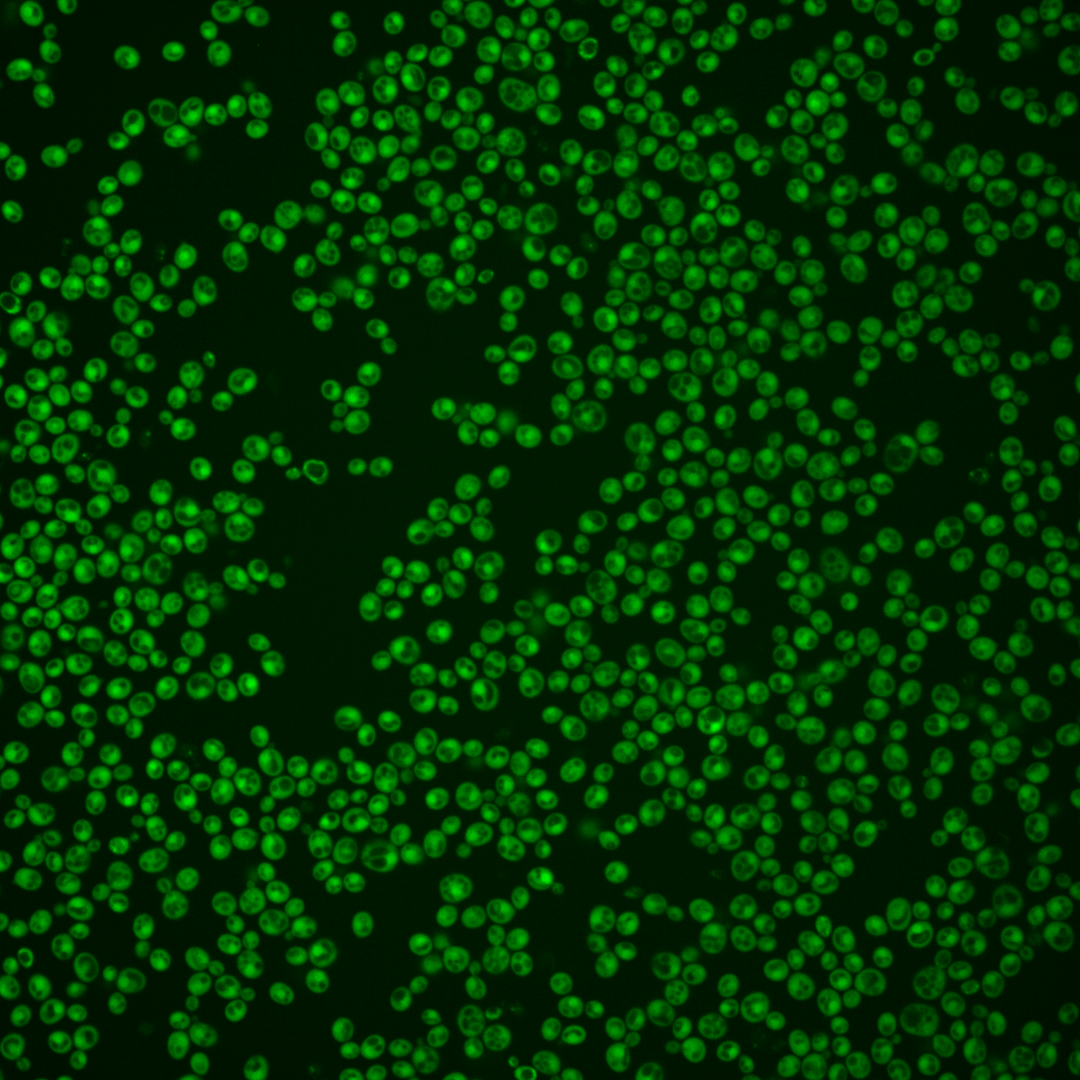
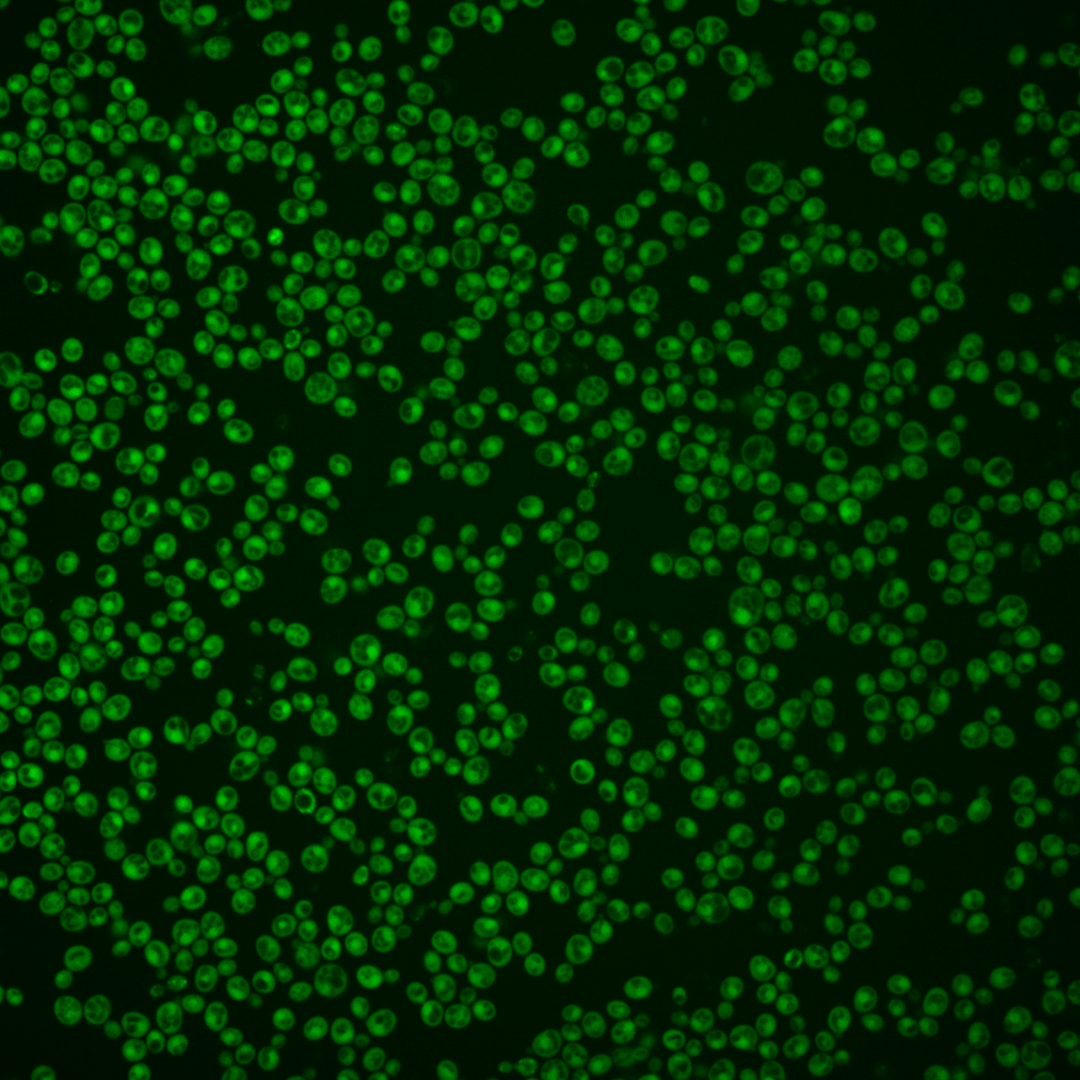
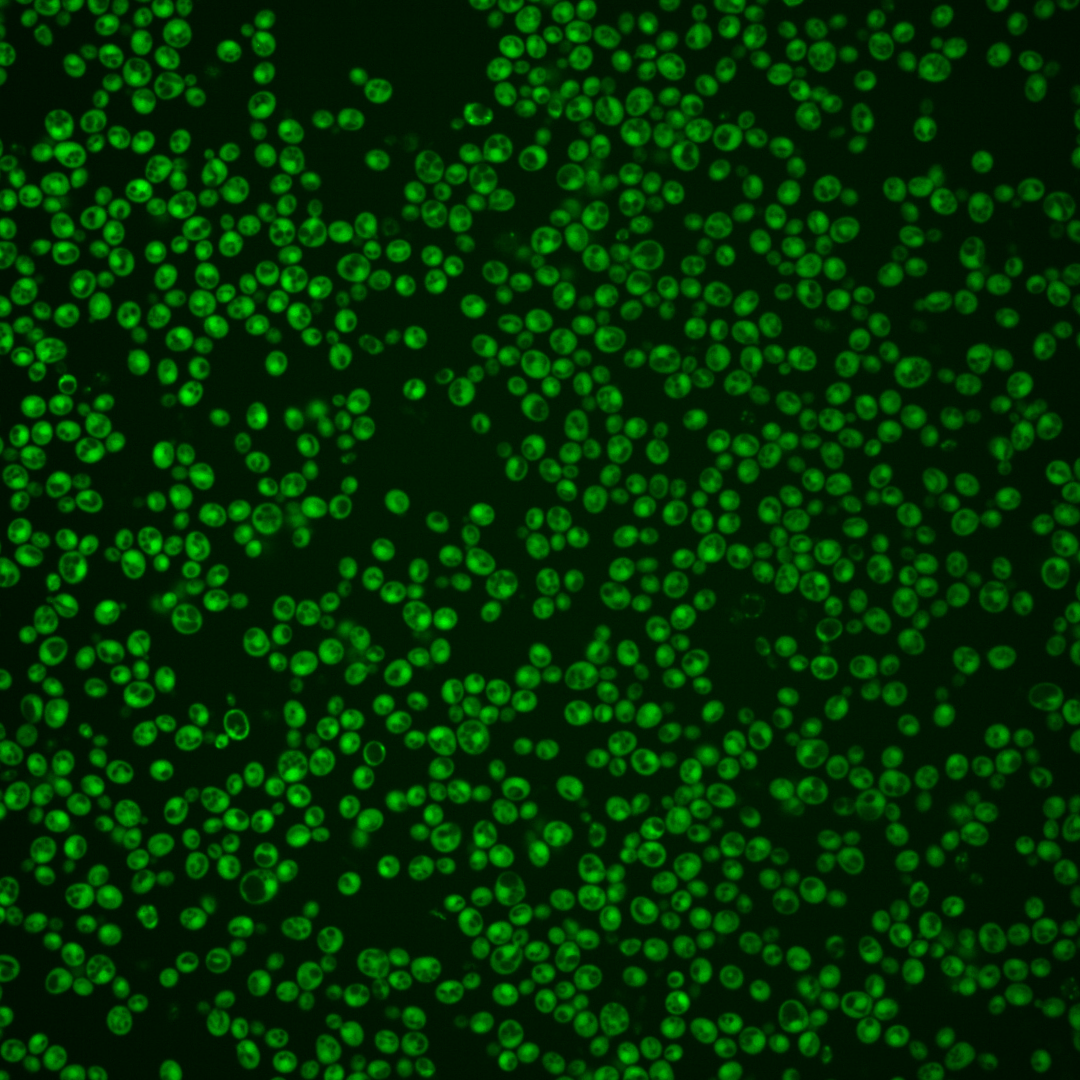
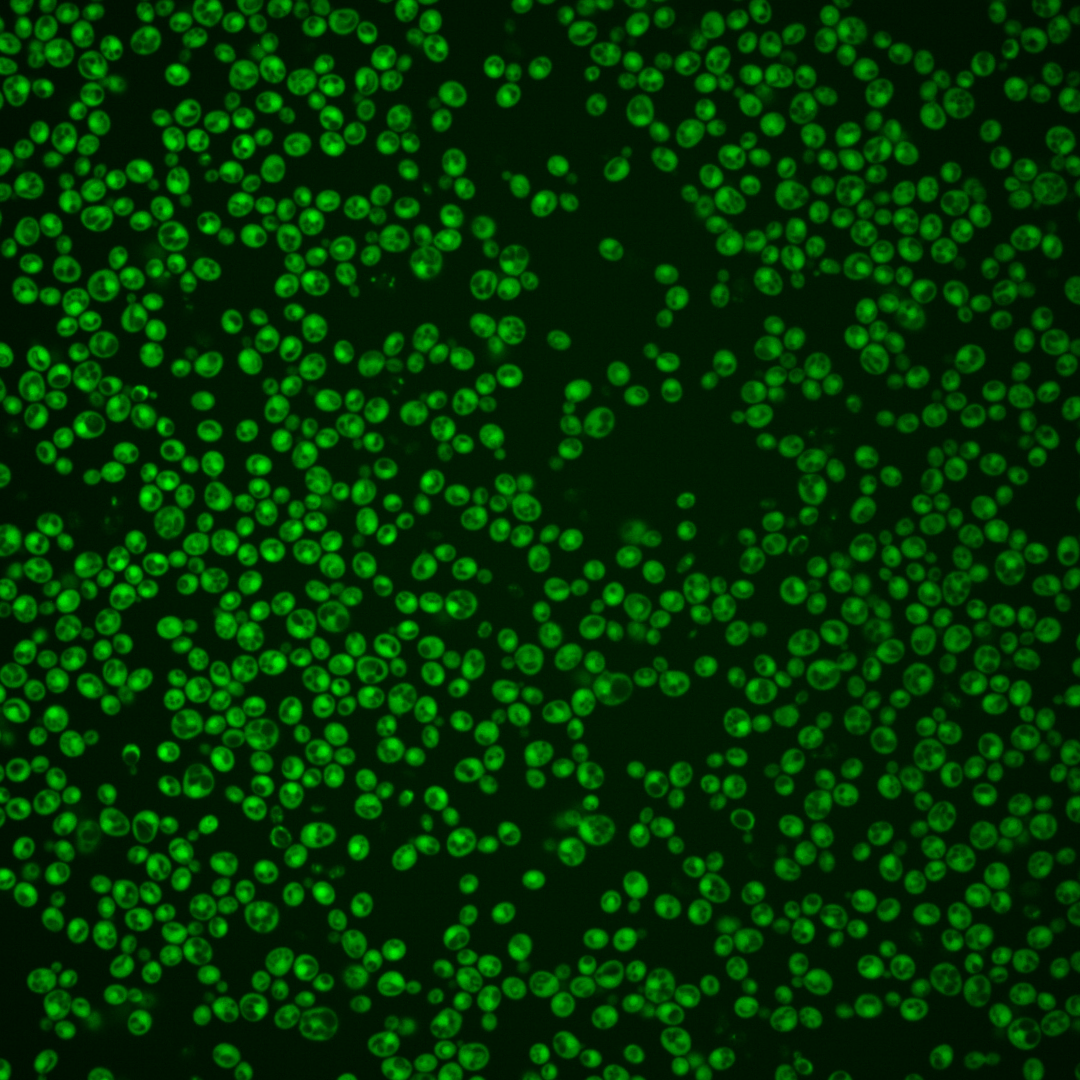
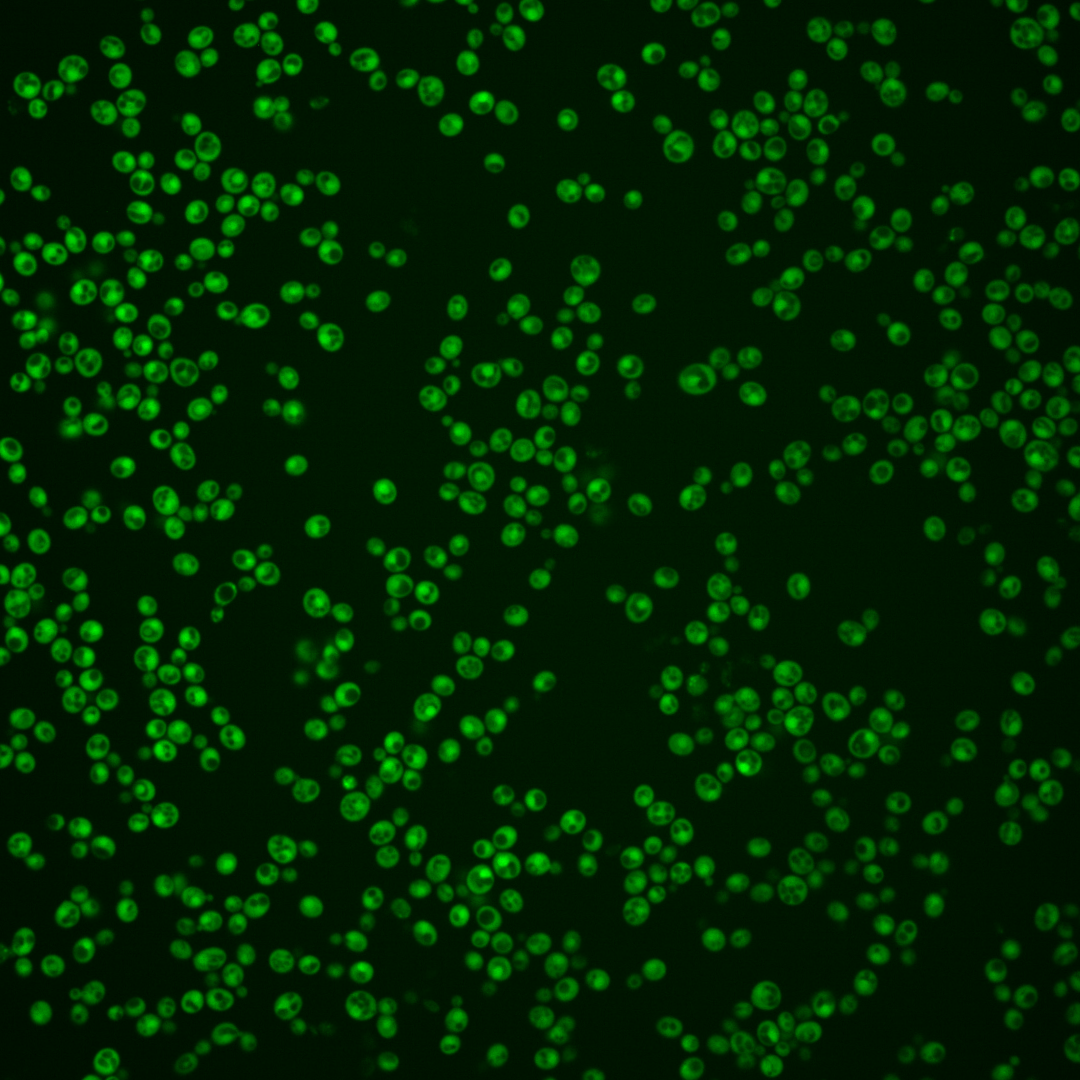
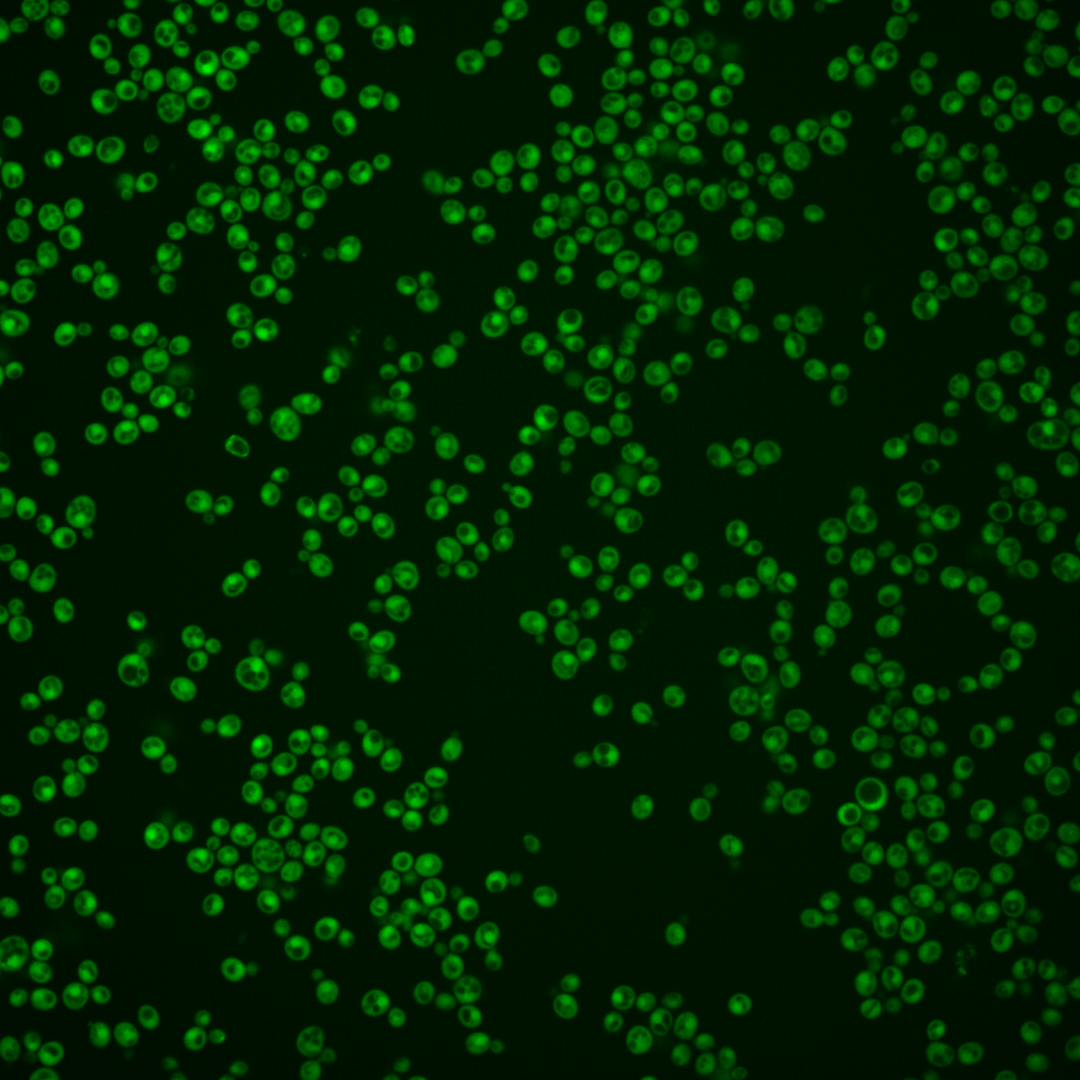
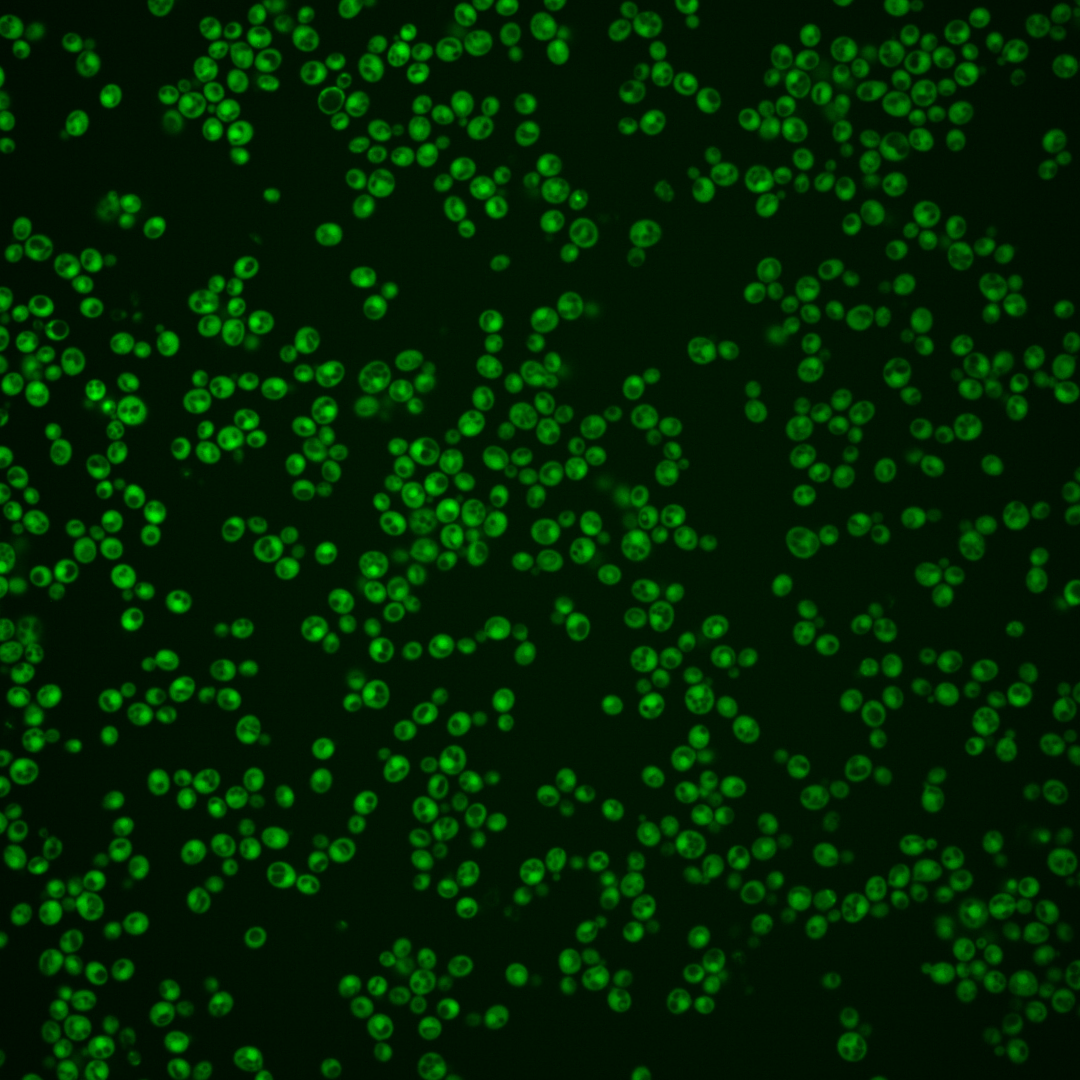
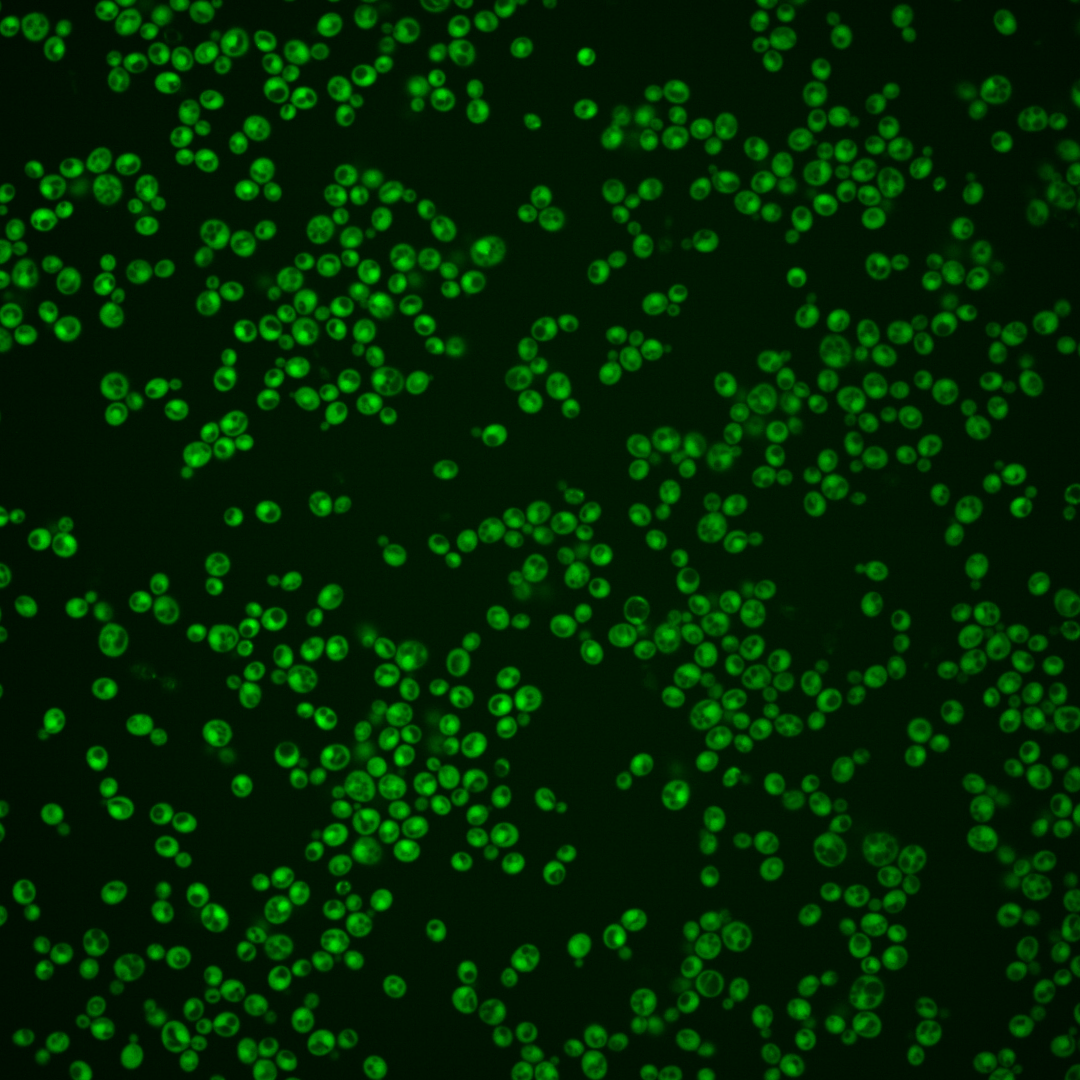

| Standard name | |
|---|---|
| Human Ortholog | |
| Description | Regulatory subunit of protein phosphatase 1 (Glc7p); involved in glycogen metabolism and chromosome segregation; proposed to regulate Glc7p activity via conformational alteration; ortholog of the mammalian protein phosphatase inhibitor 2; protein abundance increases in response to DNA replication stress |
Micrographs




















































































Sub-cellular Localization
Yeast GFP Assignment
Protein Abundance
Localization Change
External localization resources
| ensLOC | DeepLoc | |||||||||||||||||||||||
|---|---|---|---|---|---|---|---|---|---|---|---|---|---|---|---|---|---|---|---|---|---|---|---|---|
| Localization | WT1 | WT2 | WT3 | RAP60 | RAP140 | RAP220 | RAP300 | RAP380 | RAP460 | RAP540 | RAP620 | RAP700 | HU80 | HU120 | HU160 | rpd3Δ_1 | rpd3Δ_2 | rpd3Δ_3 | WT1 | WT2 | WT3 | AF100 | AF140 | AF180 |
| Cortical Patches | 0 | 0 | 0 | 0 | 0 | 0 | 1 | – | 1 | 1 | 0 | 5 | 0 | 0 | 0 | 0 | 0 | 0 | 0 | 0 | 0 | 0 | 0 | 1 |
| Bud | 0 | 0 | 0 | 0 | 0 | 0 | 0 | – | 1 | 2 | 2 | 2 | 0 | 0 | 0 | 0 | 0 | 0 | 1 | 0 | 0 | 0 | 2 | 5 |
| Bud Neck | 0 | 0 | 0 | 0 | 0 | 0 | 0 | – | 0 | 0 | 0 | 0 | 0 | 0 | 0 | 0 | 0 | 0 | 0 | 0 | 0 | 0 | 0 | 1 |
| Bud Site | 0 | 0 | 0 | 0 | 0 | 0 | 0 | – | 0 | 0 | 0 | 0 | 0 | 0 | 0 | 0 | 0 | 0 | – | – | – | – | – | – |
| Cell Periphery | 2 | 1 | 0 | 0 | 1 | 0 | 4 | – | 4 | 7 | 4 | 6 | 1 | 0 | 3 | 4 | 1 | 1 | 0 | 0 | 0 | 0 | 0 | 0 |
| Cytoplasm | 230 | 175 | 90 | 161 | 218 | 129 | 291 | – | 175 | 204 | 145 | 190 | 196 | 297 | 393 | 197 | 130 | 123 | 204 | 148 | 108 | 152 | 275 | 311 |
| Endoplasmic Reticulum | 0 | 1 | 1 | 1 | 3 | 0 | 8 | – | 3 | 16 | 5 | 12 | 1 | 0 | 3 | 11 | 2 | 3 | 0 | 0 | 0 | 0 | 2 | 8 |
| Endosome | 1 | 0 | 0 | 0 | 0 | 0 | 0 | – | 0 | 0 | 0 | 0 | 0 | 0 | 0 | 0 | 0 | 0 | 1 | 0 | 1 | 0 | 2 | 2 |
| Golgi | 2 | 0 | 1 | 0 | 0 | 1 | 1 | – | 0 | 0 | 2 | 1 | 0 | 2 | 0 | 3 | 0 | 1 | 2 | 0 | 0 | 0 | 3 | 2 |
| Mitochondria | 1 | 0 | 0 | 0 | 0 | 6 | 3 | – | 10 | 12 | 23 | 19 | 0 | 0 | 0 | 11 | 4 | 2 | 0 | 0 | 1 | 0 | 1 | 0 |
| Nucleus | 8 | 3 | 0 | 4 | 10 | 3 | 25 | – | 11 | 18 | 13 | 16 | 2 | 1 | 4 | 3 | 3 | 2 | 22 | 17 | 7 | 5 | 8 | 8 |
| Nuclear Periphery | 0 | 0 | 0 | 0 | 0 | 0 | 0 | – | 0 | 0 | 0 | 1 | 0 | 0 | 0 | 0 | 0 | 0 | 0 | 0 | 2 | 0 | 1 | 4 |
| Nucleolus | 0 | 0 | 0 | 0 | 0 | 0 | 0 | – | 0 | 1 | 0 | 0 | 0 | 0 | 0 | 0 | 0 | 0 | 0 | 0 | 0 | 0 | 0 | 0 |
| Peroxisomes | 0 | 0 | 0 | 0 | 0 | 0 | 0 | – | 0 | 0 | 0 | 0 | 0 | 0 | 0 | 0 | 0 | 0 | 0 | 0 | 0 | 0 | 0 | 0 |
| SpindlePole | 0 | 0 | 0 | 0 | 0 | 0 | 0 | – | 0 | 0 | 0 | 0 | 0 | 0 | 0 | 0 | 0 | 0 | 0 | 0 | 0 | 0 | 0 | 0 |
| Vac/Vac Membrane | 17 | 2 | 3 | 21 | 52 | 32 | 96 | – | 75 | 83 | 55 | 87 | 6 | 20 | 24 | 29 | 26 | 13 | 4 | 7 | 2 | 4 | 12 | 8 |
| Unique Cell Count | 241 | 178 | 93 | 172 | 257 | 163 | 402 | 267 | 327 | 236 | 312 | 200 | 309 | 406 | 231 | 155 | 134 | 240 | 176 | 126 | 167 | 319 | 360 | |
| Labelled Cell Count | 261 | 182 | 95 | 187 | 284 | 171 | 429 | 280 | 344 | 249 | 339 | 206 | 320 | 427 | 258 | 166 | 145 | 240 | 176 | 126 | 167 | 319 | 360 | |
Yeast GFP Assignment
Protein Abundance
| Screen | WT1 | WT2 | WT3 | RAP60 | RAP140 | RAP220 | RAP300 | RAP380 | RAP460 | RAP540 | RAP620 | RAP700 | HU80 | HU120 | HU160 | rpd3Δ_1 | rpd3Δ_2 | rpd3Δ_3 | AF100 | AF140 | AF180 |
|---|---|---|---|---|---|---|---|---|---|---|---|---|---|---|---|---|---|---|---|---|---|
| Mean Cell GFP Intensity (1e-4) | 16.8 | 16.1 | 13.0 | 13.9 | 15.8 | 10.2 | 13.6 | – | 11.9 | 12.3 | 11.3 | 12.0 | 18.9 | 17.0 | 20.4 | 22.6 | 24.1 | 22.8 | 15.4 | 16.4 | 16.7 |
| Std Deviation (1e-4) | 2.8 | 2.6 | 2.5 | 2.0 | 2.4 | 2.4 | 2.3 | – | 2.5 | 2.5 | 2.4 | 2.7 | 3.2 | 2.9 | 3.5 | 7.8 | 9.1 | 7.5 | 2.9 | 3.0 | 3.4 |
| Intensity Change (Log2) | – | – | – | 0.1 | 0.28 | -0.34 | 0.07 | – | -0.13 | -0.08 | -0.2 | -0.12 | 0.54 | 0.39 | 0.65 | 0.8 | 0.89 | 0.81 | 0.25 | 0.34 | 0.37 |
Localization Change
| Localization | RAP60 | RAP140 | RAP220 | RAP300 | RAP380 | RAP460 | RAP540 | RAP620 | RAP700 | HU80 | HU120 | HU160 | rpd3Δ_1 | rpd3Δ_2 | rpd3Δ_3 |
|---|---|---|---|---|---|---|---|---|---|---|---|---|---|---|---|
| Cortical Patches | 0 | 0 | 0 | 0 | – | 0 | 0 | 0 | 0 | 0 | 0 | 0 | 0 | 0 | 0 |
| Bud | 0 | 0 | 0 | 0 | – | 0 | 0 | 0 | 0 | 0 | 0 | 0 | 0 | 0 | 0 |
| Bud Neck | 0 | 0 | 0 | 0 | – | 0 | 0 | 0 | 0 | 0 | 0 | 0 | 0 | 0 | 0 |
| Bud Site | 0 | 0 | 0 | 0 | – | 0 | 0 | 0 | 0 | 0 | 0 | 0 | 0 | 0 | 0 |
| Cell Periphery | 0 | 0 | 0 | 0 | – | 0 | 0 | 0 | 0 | 0 | 0 | 0 | 0 | 0 | 0 |
| Cytoplasm | -1.1 | -3.0 | -3.9 | -5.0 | – | -5.9 | -6.4 | -6.4 | -6.6 | 0.6 | -0.3 | 0 | -2.9 | -3.1 | -1.5 |
| Endoplasmic Reticulum | 0 | 0 | 0 | 0 | – | 0 | 0 | 0 | 0 | 0 | 0 | 0 | 0 | 0 | 0 |
| Endosome | 0 | 0 | 0 | 0 | – | 0 | 0 | 0 | 0 | 0 | 0 | 0 | 0 | 0 | 0 |
| Golgi | 0 | 0 | 0 | 0 | – | 0 | 0 | 0 | 0 | 0 | 0 | 0 | 0 | 0 | 0 |
| Mitochondria | 0 | 0 | 0 | 0 | – | 0 | 0 | 3.1 | 0 | 0 | 0 | 0 | 0 | 0 | 0 |
| Nucleus | 0 | 0 | 0 | 0 | – | 0 | 0 | 0 | 0 | 0 | 0 | 0 | 0 | 0 | 0 |
| Nuclear Periphery | 0 | 0 | 0 | 0 | – | 0 | 0 | 0 | 0 | 0 | 0 | 0 | 0 | 0 | 0 |
| Nucleolus | 0 | 0 | 0 | 0 | – | 0 | 0 | 0 | 0 | 0 | 0 | 0 | 0 | 0 | 0 |
| Peroxisomes | 0 | 0 | 0 | 0 | – | 0 | 0 | 0 | 0 | 0 | 0 | 0 | 0 | 0 | 0 |
| SpindlePole | 0 | 0 | 0 | 0 | – | 0 | 0 | 0 | 0 | 0 | 0 | 0 | 0 | 0 | 0 |
| Vacuole | 2.4 | 3.9 | 3.7 | 4.5 | – | 5.0 | 4.7 | 4.3 | 5.0 | 0 | 1.2 | 1.0 | 2.5 | 3.2 | 1.9 |
External localization resources
Images






























Protein Concentration and Protein Localization Data
| R1 | R2 | R3 | ||||||||||||||||
|---|---|---|---|---|---|---|---|---|---|---|---|---|---|---|---|---|---|---|
| G1 Pre-START | G1 Post-START | S/G2 | Metaphase | Anaphase | Telophase | G1 Pre-START | G1 Post-START | S/G2 | Metaphase | Anaphase | Telophase | G1 Pre-START | G1 Post-START | S/G2 | Metaphase | Anaphase | Telophase | |
| Concentration | 12.0942 | 13.0767 | 11.944 | 10.9846 | 10.594 | 11.9254 | 13.5035 | 15.957 | 14.9067 | 12.756 | 10.9713 | 14.2491 | 16.4997 | 18.1255 | 16.7658 | 16.5169 | 16.6524 | 16.2864 |
| Actin | 0.0049 | 0.0001 | 0.0002 | 0.0002 | 0.0001 | 0.0006 | 0.0102 | 0.0074 | 0.0045 | 0.0018 | 0.0068 | 0.0023 | 0.0102 | 0.0001 | 0.0002 | 0.0001 | 0.0002 | 0.0019 |
| Bud | 0.0001 | 0.0001 | 0.0001 | 0.0001 | 0.0001 | 0.0005 | 0.0009 | 0.005 | 0.0053 | 0.0003 | 0.0005 | 0.0004 | 0.0002 | 0.0001 | 0.0001 | 0 | 0.0001 | 0.0001 |
| Bud Neck | 0.0006 | 0.0002 | 0.0003 | 0.0004 | 0.0005 | 0.0009 | 0.0018 | 0.0007 | 0.0007 | 0.001 | 0.0012 | 0.0014 | 0.0004 | 0.0002 | 0.0004 | 0.0004 | 0.0007 | 0.0011 |
| Bud Periphery | 0.0001 | 0 | 0 | 0 | 0 | 0.0005 | 0.001 | 0.001 | 0.0011 | 0.0002 | 0.0004 | 0.0001 | 0.0002 | 0 | 0 | 0 | 0 | 0.0001 |
| Bud Site | 0.0005 | 0.0001 | 0.0001 | 0 | 0 | 0.0001 | 0.0068 | 0.0017 | 0.0047 | 0.0004 | 0.0013 | 0.0002 | 0.0005 | 0.0001 | 0.0002 | 0 | 0 | 0.0002 |
| Cell Periphery | 0.0001 | 0 | 0 | 0 | 0 | 0 | 0.0002 | 0.0001 | 0.0001 | 0.0001 | 0.0001 | 0 | 0.0001 | 0 | 0 | 0 | 0 | 0 |
| Cytoplasm | 0.6828 | 0.7455 | 0.7175 | 0.6132 | 0.6756 | 0.5905 | 0.589 | 0.7824 | 0.7108 | 0.6939 | 0.5196 | 0.6469 | 0.6977 | 0.7683 | 0.8215 | 0.6947 | 0.779 | 0.6207 |
| Cytoplasmic Foci | 0.0045 | 0.0002 | 0.0008 | 0.0003 | 0.0005 | 0.0005 | 0.0095 | 0.0009 | 0.0043 | 0.0056 | 0.0788 | 0.0093 | 0.0024 | 0.0003 | 0.0006 | 0.0004 | 0.0005 | 0.0038 |
| Eisosomes | 0 | 0 | 0 | 0 | 0 | 0 | 0.0001 | 0 | 0 | 0 | 0 | 0 | 0 | 0 | 0 | 0 | 0 | 0 |
| Endoplasmic Reticulum | 0.0027 | 0.0012 | 0.0009 | 0.0004 | 0.0011 | 0.0028 | 0.0036 | 0.0012 | 0.0033 | 0.0101 | 0.0019 | 0.0011 | 0.0059 | 0.0005 | 0.0014 | 0.0006 | 0.0009 | 0.0019 |
| Endosome | 0.0089 | 0.0002 | 0.0005 | 0.0002 | 0.0005 | 0.0012 | 0.0352 | 0.0004 | 0.0067 | 0.0237 | 0.0832 | 0.0106 | 0.005 | 0.0001 | 0.0013 | 0.0001 | 0.0003 | 0.0035 |
| Golgi | 0.0019 | 0 | 0 | 0 | 0 | 0.0001 | 0.0067 | 0.0002 | 0.0021 | 0.0016 | 0.05 | 0.0094 | 0.0005 | 0 | 0 | 0 | 0 | 0.001 |
| Lipid Particles | 0.0061 | 0 | 0 | 0 | 0 | 0 | 0.0097 | 0 | 0.0014 | 0.0019 | 0.0234 | 0.0005 | 0.0014 | 0 | 0 | 0 | 0 | 0.0043 |
| Mitochondria | 0.0009 | 0.0001 | 0.0002 | 0.0002 | 0.0002 | 0.0023 | 0.0047 | 0.0007 | 0.0014 | 0.0007 | 0.0087 | 0.0056 | 0.0017 | 0.0001 | 0.0002 | 0.0001 | 0.0002 | 0.0017 |
| None | 0.0014 | 0.0003 | 0.0004 | 0.0003 | 0.0004 | 0.0003 | 0.0039 | 0.0005 | 0.0017 | 0.0013 | 0.0005 | 0.0011 | 0.0019 | 0.0003 | 0.0005 | 0.0003 | 0.0005 | 0.0011 |
| Nuclear Periphery | 0.0293 | 0.0135 | 0.0211 | 0.0149 | 0.0212 | 0.0266 | 0.025 | 0.0102 | 0.016 | 0.0205 | 0.0143 | 0.0151 | 0.0185 | 0.0086 | 0.0075 | 0.0072 | 0.0125 | 0.0173 |
| Nucleolus | 0.0003 | 0.0001 | 0.0001 | 0.0001 | 0.0001 | 0.0001 | 0.0006 | 0.0007 | 0.0003 | 0.0002 | 0.0002 | 0.0002 | 0.0012 | 0 | 0.0001 | 0 | 0.0001 | 0.0002 |
| Nucleus | 0.2487 | 0.2372 | 0.256 | 0.3681 | 0.2956 | 0.3699 | 0.2716 | 0.1842 | 0.2298 | 0.2281 | 0.1567 | 0.2842 | 0.2465 | 0.2202 | 0.1633 | 0.2951 | 0.2035 | 0.3354 |
| Peroxisomes | 0.0017 | 0 | 0 | 0 | 0 | 0 | 0.0018 | 0.0002 | 0.0006 | 0.0003 | 0.0462 | 0.0008 | 0.0006 | 0 | 0 | 0 | 0 | 0.0023 |
| Punctate Nuclear | 0.0029 | 0.0009 | 0.0011 | 0.0012 | 0.0025 | 0.001 | 0.0072 | 0.0018 | 0.0028 | 0.0052 | 0.0032 | 0.0095 | 0.0035 | 0.0007 | 0.001 | 0.0007 | 0.001 | 0.0026 |
| Vacuole | 0.0012 | 0.0003 | 0.0006 | 0.0003 | 0.0012 | 0.0015 | 0.0077 | 0.0006 | 0.0017 | 0.0023 | 0.0022 | 0.0009 | 0.0012 | 0.0002 | 0.0013 | 0.0001 | 0.0004 | 0.0006 |
| Vacuole Periphery | 0.0005 | 0.0001 | 0.0002 | 0.0001 | 0.0003 | 0.0006 | 0.0027 | 0.0002 | 0.0006 | 0.0007 | 0.0008 | 0.0003 | 0.0004 | 0 | 0.0002 | 0 | 0.0001 | 0.0003 |
Sequencing Data
| R1 | R2 | |||||||||
|---|---|---|---|---|---|---|---|---|---|---|
| G1 Post-START | S/G2 | Metaphase | Anaphase | Telophase | G1 Post-START | S/G2 | Metaphase | Anaphase | Telophase | |
| Gene Expression | 31.9827 | 30.0201 | 28.6409 | 38.5031 | 43.5404 | 54.3406 | 39.7484 | 43.4118 | 55.7603 | 44.9746 |
| Translational Efficiency | 4.2204 | 4.2083 | 3.3818 | 3.3379 | 3.1344 | 2.9136 | 2.6294 | 2.9782 | 2.3516 | 2.7598 |
Hit Data
| Dataset | Hit |
|---|---|
| Protein Concentration | ✔ |
| Protein Localization | ✔ |
| Gene Expression | ✘ |
| Translational Efficiency | ✘ |
Endocytosis
| Temp | Actin Patch (Sac6-tdTomato) | Cortical Patch (Sla1-GFP) | Late Endosome (Snf7-GFP) | Vacuole (Vph1-GFP) |
|---|---|---|---|---|
| 37℃ | ||||
| RT |
Cell Cycle Omics
CYCLoPs (Glc8-GFP)
| Gene / Allele | Actin Patch (Sac6-tdTomato) | Cortical Patch (Sla1-GFP) | Late Endosome (Snf7-GFP) | Vacuole (Sac6-tdTomato) |
|---|
| Gene | Images |
|---|
| Gene | Images |
|---|
Images are not yet available
Images are not yet available